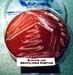

Página
4 de 5 |
| Curso de Enfermedades Infecciosas Porcinas Galería Fotográfica - Otras Enfermedades Bacterianas |
Página
4 de 5 |

|

|

|

|

|
| Orquitis | Pig | Piojo | Rosa bengala | Suis |
|

|

|

|

|
| Suis sangre | T. articular | T. articular 2 | T. bazo | T. higado |